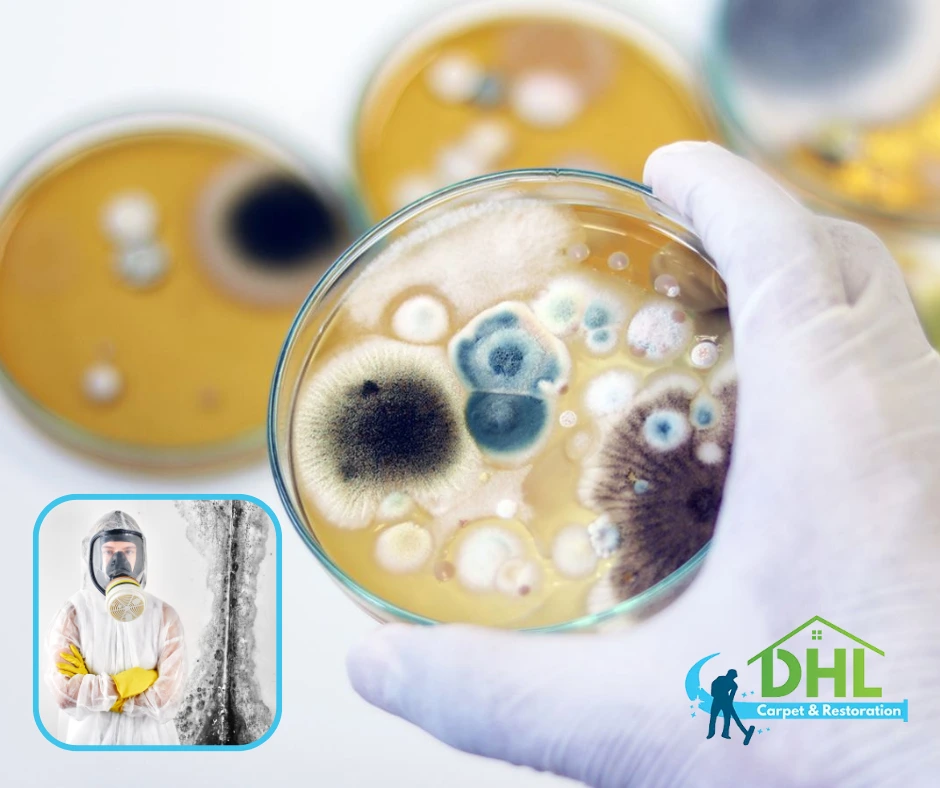

Mold infestations strike fast when moisture and organic matter meet. Experts study these events to stop problems early. Homeowners who act quickly reduce health risks and property damage. Effective mold remediation requires careful monitoring and swift action. In many cases, mold remediation can stop a small issue from growing into a major headache.
Spore Growth in Action
Mold spores live everywhere, but they spring to life when conditions become right. They settle on surfaces as moisture rises. Warm temperatures and high humidity speed up growth. Scientists observe that factors like airflow and surface type drive spore development. Professionals use these insights to plan mold remediation that targets the cause. Homeowners benefit from knowing the triggers and act fast to control moisture. This active approach breaks the cycle of spore expansion.
Environmental Triggers and Active Defense
Moisture, temperature, and poor ventilation fuel mold infestations. When leaks occur, spores find a home and begin to multiply. Homeowners who monitor humidity and repair water damage reduce the risk. They choose mold remediation that uses natural methods and eco-friendly cleaners. This process stops mold from thriving by tackling the root causes. A focused mold remediation plan emphasizes airflow, temperature control, and immediate repairs. Action-packed measures like these ensure that mold does not settle in the first place.
Practical Tactics for Fast Mold Remediation
Owners and managers must act decisively. They should inspect areas prone to dampness and seal leaks immediately. Many experts recommend mold remediation to restore safe, dry environments. They install dehumidifiers and improve ventilation. These steps actively prevent mold from regaining a foothold. Using natural antifungal products also proves effective. Each task contributes to a comprehensive mold remediation plan that stops mold growth at its source. By maintaining a vigilant approach, individuals keep the balance between indoor air quality and environmental health intact. Recent studies show that regular checks and quick fixes reduce mold outbreaks and lower maintenance costs. This proactive method of mold remediation empowers property owners and builds lasting defenses against infestations.
A thorough look at mold behavior reveals that small changes in moisture or temperature spark rapid spore growth. Experts encourage regular inspections and prompt repairs. Homeowners using timely mold remediation often avoid expensive repairs later. They benefit from knowing the warning signs and taking action before mold spreads. Active management transforms a reactive cleanup into a strategic defense. The science of mold spore development guides these efforts, ensuring that each mold remediation step hits the mark. With ongoing research and practical experience, experts continue to refine these methods, making mold remediation more efficient and accessible.
By taking charge, you can keep mold at bay. Use the proven strategies above to manage mold infestations effectively. Embrace a routine of vigilance and prompt repairs. This mindset forms the backbone of successful mold remediation.
Learn more about mold remediation:
How Mold Spores Spread Indoors: Key Factors for Effective Mold Remediation